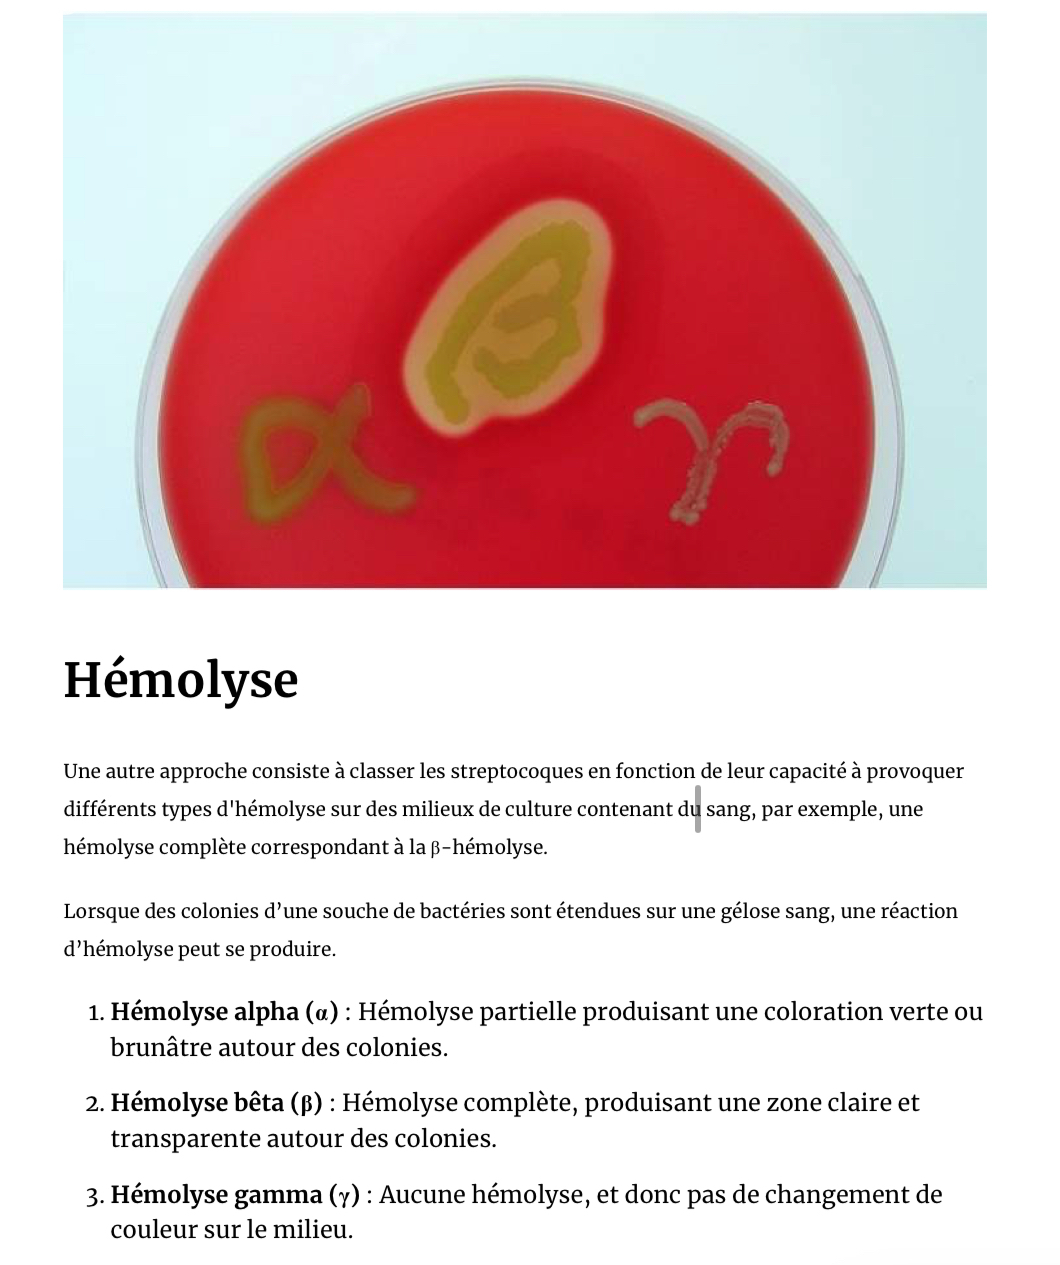

Quelle couche externe de la bacterie protege contre les attaques du systeme immunitaire ?
capsule
Quelle structures permettent la bacterie dinfecter la hote et coloniser ? (2)
Flagelles (mobilité)
Fimbriae (attachement aux cell hotes)
Qsk qui permet le transfert de materiel genetique dune cell a une autre ?
Les pili
Quel test permet de distinguer le staphylococcus aureus ?
test de la coagulase
Le test de la coagulase est utile pour distinguer le Staphylococcus aureus, qui produit l’enzyme
coagulase, des staphylocoques moins pathogènes qui n’en produisent pas. Ce test est simple et
relativement rapide et permet une identification présomptive de l’espèce pour les Staphylococcus
spp. (coagulase + vs -
Quels sont les criteres de classification des streptocoques ? (2)
1) Classification Lancefield (A, B…)
2) capacité d’hémolyse
Quels sont les diff reactions d’hémolyse ? (3)
alpha - partielle
beta - complète
gamma - abscente
En quelle couleur apparaissent les cell gram positif et gram negatif ?
gram + violette
gram - Rouge (a cause de la safranine)



